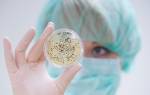

Это сегодня благодаря мощным электронным микроскопам и современным методам исследования мы знаем, что представляют собой мельчайшие живые организмы нашей планеты ─ бактерии. А как врачи и ученые объясняли распространение инфекционных заболеваний 250 лет назад? И кто первым описал и открыл бактерии, попытался их изучить?
Как объясняли возникновение инфекционных заболеваний в древности
На протяжении многих столетий человечество не только не имело защиты от инфекционных заболеваний, а и не признавало их как заболевание вообще. Считалось, что они являются «карой божьей за грехи». Единственным плюсом было то, что таких больных старались изолировать. Врачами того времени было подмечено, что изоляция тем самым препятствует распространению болезни. Это дало возможность рассматривать распространение инфекции как заболевание. Так итальянский лекарь Джироламо Фракасторо первым предположил, что заболевание переходит от больного к здоровому через предметы и может передаваться на расстоянии. Он даже выдвинул гипотезу, что существуют маленькие организмы, способные передвигаться по воздуху, попадая в определенную среду, они начинают там размножаться. Таким образом, они являются разносчиками инфекции. Но только с изобретением первого микроскопа научно было доказано, что бактерии действительно существуют.
Врачи и ученые единодушны в том, что открытие и описание бактерий стало важным шагом в развитии медицины и микробиологии. Первым, кто увидел и описал эти микроорганизмы, был голландский ученый Антони ван Левенгук в XVII веке. Используя собственноручно изготовленные микроскопы, он наблюдал за каплями воды и зубным налетом, обнаруживая в них живые существа, которые позже были названы бактериями. Врачи отмечают, что его открытия стали основой для дальнейших исследований, которые привели к пониманию роли бактерий в заболеваниях и их лечении. Это открытие открыло новые горизонты в борьбе с инфекциями и стало основой для развития антибиотикотерапии. Врачи подчеркивают, что вклад Левенгука в науку невозможно переоценить, так как он положил начало целой эпохе в изучении микробов и их влияния на здоровье человека.

Изобретение первого микроскопа
Первый увеличительный прибор, благодаря которому были обнаружены бактерии, изобрел голландский натуралист-самоучка Антони ван Левенгук. Именно он был тем, кто описал и открыл бактерии. Все началось с его увлечения экспериментировать с увеличительными стеклами. До него изготовленные линзы были способны увеличивать предмет лишь в 20 раз. Его же «микроскопы» могли увеличивать изучаемый предмет в 200-300 раз. Первые увеличительные приборы были размером с горошину и вставлялись в оправу. Пользоваться ими было довольно сложно, но несмотря на это, увеличение было для того времени достаточно четким и точным.
Антони ван Левенгук всю свою жизнь занимался усовершенствованием своих увеличительных приборов. После смерти 26 микроскопов он завещал Лондонской академии наук.
Вклад ученого в микробиологию
Ученый-самоучка изучал все, что ему было интересно: листья растений, частички своей кожи, кровь, насекомых и т.п. Однажды, исследовав каплю дождевой воды, которая простояла в кувшине, он обнаружил удивительно маленьких, но живых «зверьков», которые были разной формы и беспорядочно двигались. Так в 1683 году были впервые обнаружены, а позднее описаны бактерии.
Ученый сделал целый ряд открытий, уникальных для своего времени.
- Маленькие живые существа (бактерии) живут повсюду и могут переноситься воздушным путем.
- При нагревании жидкости «зверьки» перестают двигаться, а после охлаждения они вновь не оживали. Значит, они могут существовать при определенной температуре, ее изменение может привести к их гибели.
- Маленькие существа имеют разную форму: одни круглые, другие в виде палочек, завитков. Некоторые из них живут одиночно, некоторые образуют пары, группы. Одни из них не двигаются, другие совершают движение.
- Очень хотелось ученому сделать описание органов, но из-за малого увеличения ему это так и не удалось. Но чтобы высчитать размеры, он придумал сравнить размеры «зверьков» с размерами песчинки.
За 50 лет исследований ученый описал более 200 видов микроорганизмов, внеся тем самым неоценимый вклад в развитие микробиологии. До сих пор остается загадкой, как при таком по современным меркам небольшом увеличении ученый смог так подробно изучить и описать эти виды.
Многие люди считают, что открытие бактерий стало одним из важнейших шагов в развитии микробиологии. В основном, это заслуга голландского ученого Антони ван Левенгука, который в 1676 году впервые описал микроскопические организмы, наблюдая их через свой самодельный микроскоп. Его наблюдения произвели настоящий фурор в научном сообществе. Некоторые считают, что его открытия стали основой для дальнейших исследований в области медицины и биологии. Однако стоит отметить, что до Левенгука существовали и другие ученые, которые делали первые шаги в изучении микромира, хотя и не имели таких же точных инструментов. В итоге, открытие бактерий стало результатом совместных усилий многих исследователей, и его значение трудно переоценить.

Признание великого ученого
Свою миссию в признании ученого-самоучки сделал доктор Грааф. Именно он в 1673 году написал в Лондонское королевское общество письмо, в котором говорилось об ученом, который изобрел микроскоп, не имеющий аналогов. Королевский двор нашел Антони ван Левенгука, и между ними установилась переписка. За 50 лет переписки ученым было отправлено множество писем с подробным описанием своих исследований. В начале переписки описанное ученым подвергалось сомнениям других ученых. Но в ходе проверки была установлена правдивость всего описанного в письмах.
И в 1680 году ученый-самоучка стал равноправным членом Лондонского королевского двора, а позднее и Французской академии наук. Посмотреть на его удивительные увеличительные приборы приезжали не только ученые, а и многие правители.
Другие открытия ученого
Кроме того что он впервые обнаружил и описал микроорганизмы, ему принадлежит и ряд других открытий. Так он первый обнаружил в крови эритроциты и подробно это описал в своих трудах. Им впервые были обнаружены и описаны сперматозоиды. Он подробно изучил мышечные волокна и установил, что они бывают разные по своей структуре.
Работы ученого печатались во многих известных изданиях того времени. Его письма еще в те годы были переведены на латинский язык и опубликованы при жизни.
Левенгук вошел в историю как первооткрыватель удивительного мира бактерий и как величайший экспериментатор своего времени. Сегодня микробиология шагнула далеко вперед в изучении и описании бактерий, но до сих пор осталось множество неизученных видов, которые являются нераскрытыми тайнами из мира бактерий.

Вопрос-ответ
Когда были впервые обнаружены бактерии?
Бактерии были впервые обнаружены в 1676 году голландским ученым Антони ван Левенгуком, который использовал простейший микроскоп для изучения капли воды и описал различные микроорганизмы, включая бактерии.
Какое значение имеет открытие бактерий для науки?
Открытие бактерий стало основополагающим для развития микробиологии, медицины и экологии. Оно открыло новые горизонты в понимании процессов, таких как разложение органических веществ, болезни, а также взаимодействие микроорганизмов с окружающей средой и организмами.
Кто еще внес значительный вклад в изучение бактерий после Левенгука?
После Левенгука значительный вклад в изучение бактерий внесли такие ученые, как Луи Пастер, который разработал методы стерилизации и вакцины, и Роберт Кох, который установил причинные связи между бактериями и болезнями, что стало основой для медицинской микробиологии.
Советы
СОВЕТ №1
Изучите биографию Антони ван Левенгука, который считается первым человеком, описавшим бактерии. Его эксперименты с микроскопами и наблюдения за микроорганизмами стали основой микробиологии.
СОВЕТ №2
Обратите внимание на развитие микроскопии. Понимание того, как технологии микроскопов эволюционировали с тех пор, поможет вам лучше понять, как ученые открывали новые виды бактерий и другие микроорганизмы.
СОВЕТ №3
Исследуйте влияние открытия бактерий на медицину и науку. Понимание роли бактерий в здоровье человека и экосистемах поможет вам оценить важность этих микроорганизмов в современном мире.
СОВЕТ №4
Посмотрите документальные фильмы или прочитайте книги о микробиологии. Это поможет вам глубже понять, как бактерии влияют на нашу жизнь и окружающую среду, а также познакомит с современными исследованиями в этой области.